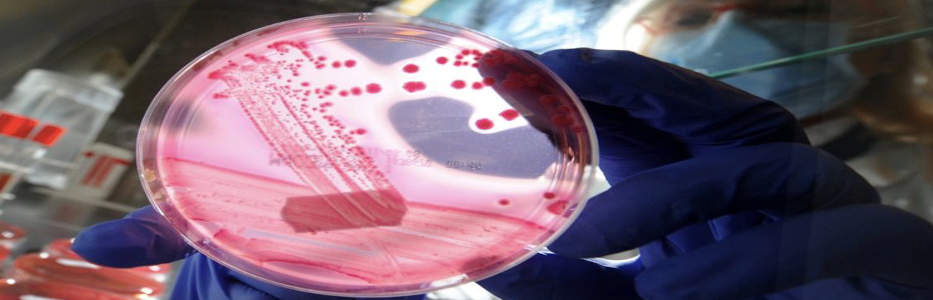

Testing tool could help doctors break chain during superbug outbreaks

CHICAGO: When it comes to stopping the outbreak of a dangerous drug-resistant “superbug” bacteria, doctors…
CHICAGO: When it comes to stopping the outbreak of a dangerous drug-resistant “superbug” bacteria, doctors…